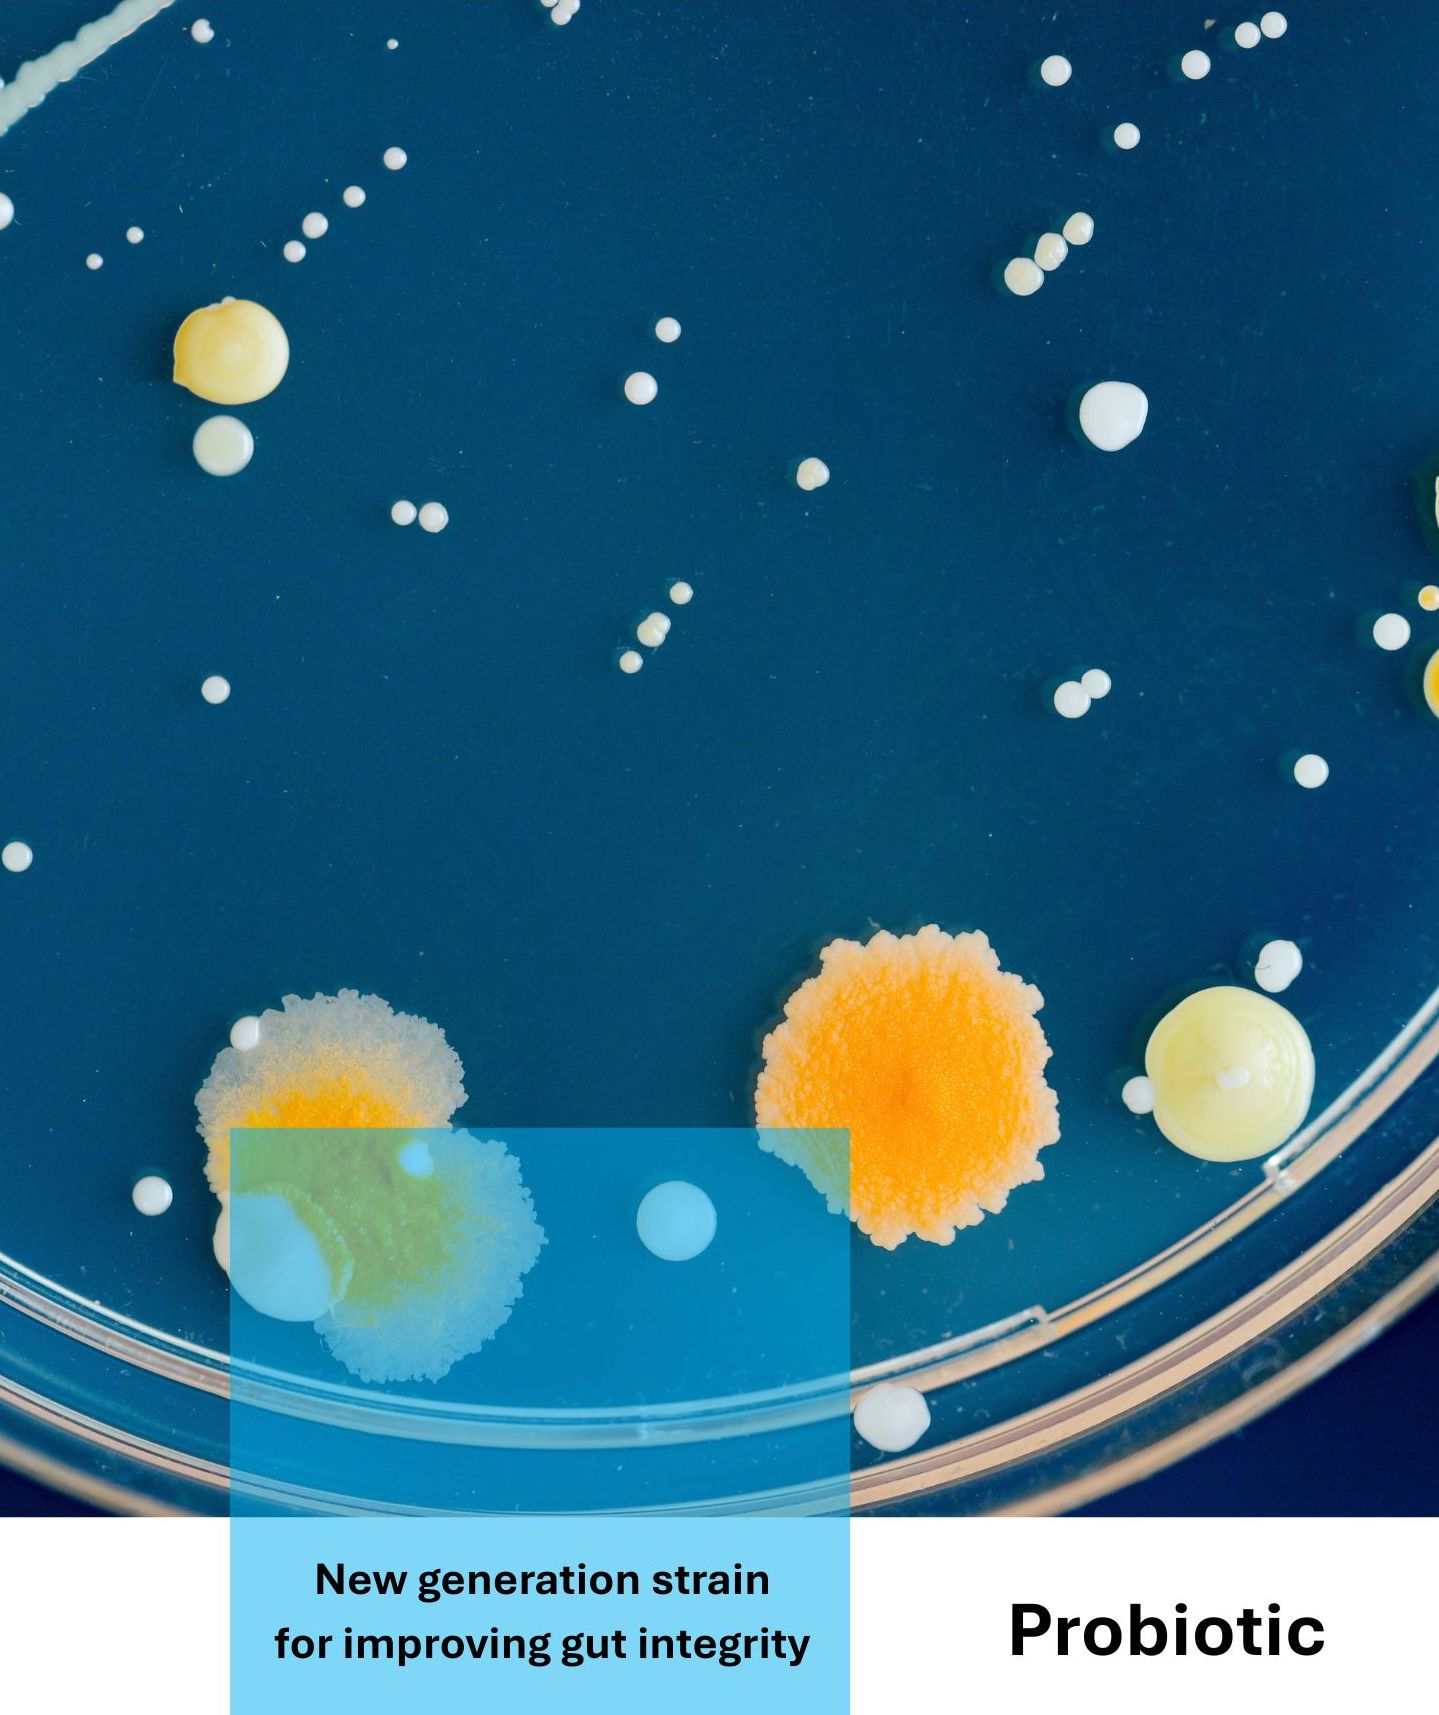

At Stiinta LLC, we see animal nutrition as the foundation of healthier livestock, sustainable farming, and a stronger food system. Through science-driven solutions, we improve feed efficiency, enhance animal welfare, and support long-term productivity—delivering smarter nutrition, healthier animals, and a sustainable future.
Enzyme
Unlocking nutrients, powering performance.





Gut Health Solution
(MSFA + Probiotic/ Prebiotic/Postbiotic)

Acidifier
Balancing digestion, boosting resilience



Anti-Stress
Reducing stress, enhancing resilience



